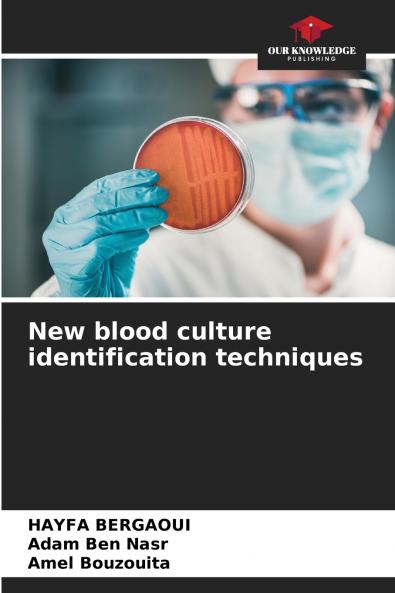
New blood culture identification techniques

English
Paperback
₹6709
₹8681
22.72% OFF
(All inclusive*)
Delivery Options
Please enter pincode to check delivery time.
*COD & Shipping Charges may apply on certain items.
Review final details at checkout.
Looking to place a bulk order? SUBMIT DETAILS
Delivery Options
Please enter pincode to check delivery time.
*COD & Shipping Charges may apply on certain items.
Review final details at checkout.
About The Book
Description
Author(s)
Bacteremia is the leading cause of death in intensive care units. The development of rapid methods can reduce mortality due to delays in appropriate antibiotic therapy. Matrix-Assisted Laser Desorption Ionization Time-Of-Flight polymerase chain reaction and fluorescence in situ hybridization are the main techniques used. Liquid chromatography coupled to tandem mass spectrometry gas chromatography coupled to an ion mobility spectrometer and ImmulexTM are less frequently used identification techniques. Real-time video imagingFASTinov®Uro4 HB&LTM system Fluorogenic probe Direct & Rapid Antimicrobial Susceptibility Test systemScattered Light Integrated Collection. Knowledge of the performance of the methods used is essential to their control and reliability. Laboratory implementation of these techniques must be carefully adapted to a number of factors including the hospital laboratory capabilities clinicians and patient population.
Details
ISBN 13
9786208229795
Publication Date
-25-10-2024
Pages
-68
Weight
-106 grams
Dimensions
-152x229x4.14 mm